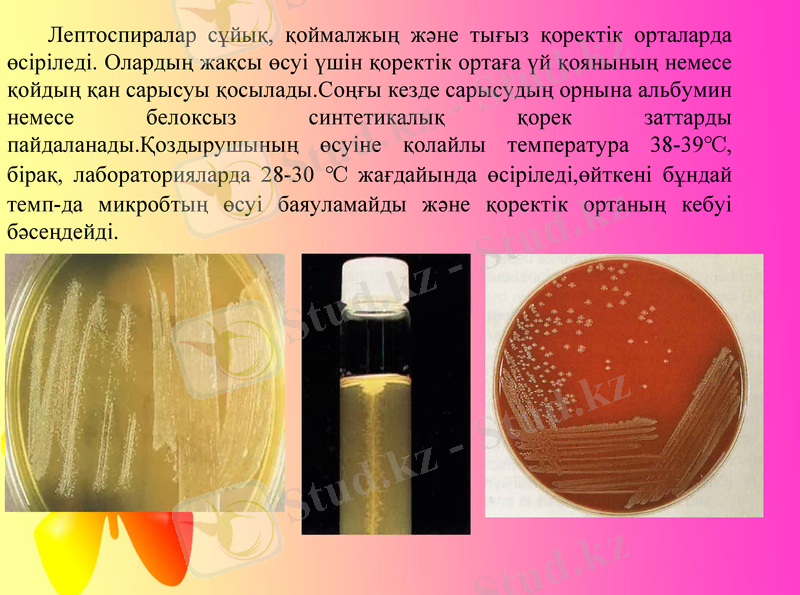
Slide 8

Лептоспироз: қоздырғышы, клиникалық-патанатомиялық ерекшеліктері, ем және алдын-алу



Қазақстан Республикасы Білім және Ғылым Министрлігі Семей қаласының Шәкәрім атындағы Мемлекеттік Университеті
Тақырыбы: Лептоспироз
БӨЖ
Орындаған: Онгарова Д. Б.
Тобы: ВС-303
Тексерген:Омарбеков Е. О.
Семей 2017 жыл

Жоспар

Кіріспе
Лептоспироз - үй жануарлары мен көптеген кәсіптік, жабайы аңдардың және адамның зооантропоноздық, табиғи-ошақтық жұқпалы ауруы.
Адамдар мен жануарлардың ағзаларына лептоспиралар терінің аздаған жарақаты және жарақатталмаған ауыз қуысының, мұрынның, көздің, ішек-қарынның және несеп ағар жүйелерінің кілегейлі қабықтары арқылы енеді.
Аурудың клиникалық белгілері мен патологоанатомиялық өзгерістер, жануарлардың қанынан спецификалық антиденелердің табылуы шаруашылықтың лептоспироздан қолайсыз болуына негіз болады. Лептоспирозға диагноз барлық жағдайларда лабораториялық зерттеулермен расталады.

Лептоспироз
Лептоспироз - үй жануарлары мен көптеген кәсіптік, жабайы аңдардың және адамның зооантропоноздық, табиғи-ошақтық жұқпалы ауруы. Лептоспирозбен мүйізді ірі қара, шошқа, жылқы, қой, бұғы, ит, түлкі және жануарлардың басқа түрлері ауырады.

Лептоспиралар сұйық, қоймалжың және тығыз қоректік орталарда өсіріледі. Олардың жақсы өсуі үшін қоректік ортаға үй қоянының немесе қойдың қан сарысуы қосылады. Соңғы кезде сарысудың орнына альбумин немесе белоксыз синтетикалық қорек заттарды пайдаланады. Қоздырушының өсуіне қолайлы температура 38-39℃, бірақ, лабораторияларда 28-30 ℃ жағдайында өсіріледі, өйткені бұндай темп-да микробтың өсуі баяуламайды және қоректік ортаның кебуі бәсеңдейді.


ІНДЕТТІК ЕРЕКШЕЛІКТЕРІ

ДЕРТТЕНУІ

Өтуі және симптомдары

Лептоспироздың өтуі мен симптомдарының малдың әр түлігінде өз ерекшеліктері бар:

Патологоанатомиялық өзгерістер

БАЛАУ


Лептоспирозды уақытында анықтау мақсатында жануарлардың қан сарысуына микроаглютинация реакциясын (кейін - МАР) жүргізеді:

Лабораториялық зерттеулердің нәтижесі бойынша шаруашылық (ферма, табын) келесі жағдайларда лептоспироздан қолайсыз болып саналады:

Лептоспироздың салдарынан іш тастау (өлі туу) болған деп есептеледі, егер анықталса:

ЕМІ

Лептоспирозға бейім барлық жануарларды келесі жағдайларда вакцинациядан өткізеді:
1) лептоспироздан қолайсыз шаруашылықтарда;
2) мал бастарын лептоспирозға тексермей жинақтайтын бордақылау шаруашылықтарында;
3) лептоспироздың табиғи ошағының аймағында мал жайылғанда;
4) шаруашылықтардағы жануарлардың қанынан МАР-сына оң көрсеткенде;
5) отарлы мал шаруашылықты аудандарда.

Эпизоотиялық ошақтарда және қолайсыз пункттерде жүргізілетін шаралар
Шектеудің шарттары бойынша болмайды:
1) жануарларды өсіру, халыққа сату үшін сыртқа шығаруға;
2) шаруашылыққа қызмет көрсететін ветеринариялық маманның рұқсатынсыз қайтадан топтастыруға;
3) жануарларды тоғандарға жіберуге және жануарлардың тоғандардан су ішуіне, шомылуына;
4) вакцинация жасалмаған жануарларды, лептоспирозбен ауырған жануарлар жайылған жайылымға жаюға немесе лептоспироздың табиғи ошағы аумағында жаюға;
5) вакцинация жасалмаған жануарларды ішінде лептоспироз жұқтыратын кеміргіштер ластаған азықпен азықтандыруға.

Ветеринариялық-санитариялық қолайлы аумақтарда жүргізілетін алдын-алу шаралары
Жануарлардың лептоспироз ауруына жол бермеу мақсатында меншік және мал иелері, ветеринариялық мамандар келесі шараларды жүзеге асырады:
1) жануарлардың клиникалық жағдайын бақылап, іш тастаудың санын ескереді және лептоспирозға күдікті жағдайда лабораториялық зерттеу үшін патологиялық материал алуды іске асырады;
2) тұқымдық шаруашылықтарды (фермалар), кәсіпорындарды, қолдан ұрықтандыру станцияларын лептоспироздан қолайлы шаруашылықтардан жинақтауға;
3) шаруашылыққа келген барлық жануарларды 30 күндік карантин ішінде лептоспирозға МАР-сымен сарысуды 1:25 қатынаста зерттейді. Шаруашылыққа тұқымдық мақсатқа әкелген шошқаларды серологиялық зерттеудің нәтижесіне қарамастан микроскопиялық жолмен лептоспира тасығыштыққа тексереді. Жануарлардың қандарының сарысуында өзіндік антидене болса немесе несебімен лептоспиралар бөлінсе лептоспироздан қолайсыз шаруашылықтар үшін қаралған шараларды жүргізіледі;
4) бордақылау шаруашылықтарына дені сау жануарларды лептоспирозға тексермей жинақтауға рұқсат етіледі, бірақ карантин кезінде олар міндетті түрде лептоспирозға қарсы егіледі;
5) жануарларды лептоспироздан қолайсыз шаруашылық жүргізуші субъектілердің, елді мекендердің малдарымен жайылымдарда, суаратын жерлерде жанасуына тиым салынады; егілмеген жануарларды лептоспироздың табиғи ошағының аумағында бағуға болмайды;
6) тоғандардың жағасында жануарлар үшін жазғы лагерлер құруға болмайды;
7) шаруашылық жүргізуші субъектілердің аумағында мал шаруашылығы үй-жайларында және азық сақтау орындарында үнемі кеміргіштерді жойып отырады.

ҚОРЫТЫНДЫ
Ауру және ауруға күдікті жануарларды оқшаулап, гипериммунды сарысумен және антибиотиктермен қолдану нұсқаушасында көрсетілген дозаларда емдейді. Мұндай жануарларды санитариялық қасапханада сояды, егер ет өңдейтін кәсіпорынның сою цехында ол болмаса, сау жануарлардың өнімдерін цехтан алып кеткеннен кейін жұмыс аяғында жеке алдын-алу шараларын сақтап сояды. Цехтың ішін және жабдықтарды мұндай жануарлар сойылғаннан кейін залалсыздандырады.

ПАЙДАЛАНЫЛҒАН ӘДЕБИЕТТЕР
1. Сайдулдин Т. Індеттану және жануарлардың жұқпалы аурулары. - Алматы: “Полиграфия-сервис К°”, 2009.
2. Сайдулдин Т. Жануарлардың жұқпалы және аса қауіпті аурулары. - Алматы: “Полиграфия-сервис К°”, 2013.
3. Қасымов Е. И. Індеттану және инфекциялық аурулармен күрес шаралары. - Алматы, 2009.
4. Ветеринариялық заңдылықтар. 1, 2, 3- том. - Астана, 2004.
- Іс жүргізу
- Автоматтандыру, Техника
- Алғашқы әскери дайындық
- Астрономия
- Ауыл шаруашылығы
- Банк ісі
- Бизнесті бағалау
- Биология
- Бухгалтерлік іс
- Валеология
- Ветеринария
- География
- Геология, Геофизика, Геодезия
- Дін
- Ет, сүт, шарап өнімдері
- Жалпы тарих
- Жер кадастрі, Жылжымайтын мүлік
- Журналистика
- Информатика
- Кеден ісі
- Маркетинг
- Математика, Геометрия
- Медицина
- Мемлекеттік басқару
- Менеджмент
- Мұнай, Газ
- Мұрағат ісі
- Мәдениеттану
- ОБЖ (Основы безопасности жизнедеятельности)
- Педагогика
- Полиграфия
- Психология
- Салық
- Саясаттану
- Сақтандыру
- Сертификаттау, стандарттау
- Социология, Демография
- Спорт
- Статистика
- Тілтану, Филология
- Тарихи тұлғалар
- Тау-кен ісі
- Транспорт
- Туризм
- Физика
- Философия
- Халықаралық қатынастар
- Химия
- Экология, Қоршаған ортаны қорғау
- Экономика
- Экономикалық география
- Электротехника
- Қазақстан тарихы
- Қаржы
- Құрылыс
- Құқық, Криминалистика
- Әдебиет
- Өнер, музыка
- Өнеркәсіп, Өндіріс
Қазақ тілінде жазылған рефераттар, курстық жұмыстар, дипломдық жұмыстар бойынша біздің қор #1 болып табылады.



Ақпарат
Қосымша
Email: info@stud.kz